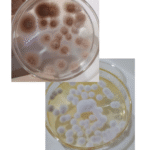
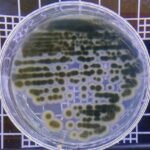
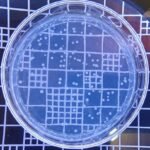
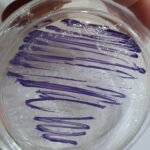
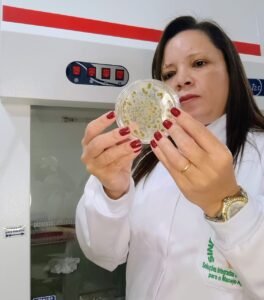

E-book: Manual Completo de Produção de Bioinsumos On-Farm: Para Agricultores e Profissionais de Biofábricas

Do entendimento do microrganismo à aplicação segura no campo, com critério técnico-científico e foco em resultados reais.
👉 Se você já tentou produzir bioinsumos on-farm e teve resultados inconsistentes, insegurança na aplicação ou dúvidas sobre o que realmente estava cultivando, o problema não é a técnica on-farm.
O problema é produzir sem critério microbiológico.
Este manual é para você que:
✓ Já tentou produzir bioinsumos on-farm e teve resultado inconsistente
✓ Segue “receitas da internet”, mas não sabe se está fazendo certo
✓ Tem medo de contaminação, falhas no processo ou prejuízo no campo
✓ Produz bioinsumos, mas não entende totalmente o microrganismo
✓ Quer reduzir custos sem comprometer qualidade e segurança
Se você já pensou algo parecido com isso…
“Será que a água que eu uso interfere na multiplicação dos microrganismos?”
“E se eu estiver multiplicando o microrganismo errado para o problema que tenho no campo?”
“Tenho vontade de produzir meus próprios bioinsumos, mas não sei por onde começar.”
“Será que posso usar o mesmo tempo de multiplicação para todos os microrganismos?”
Você não precisa de mais receitas. Você precisa de um método!
Este manual foi estruturado para conduzir você por um processo lógico e seguro, evitando erros comuns na produção de bioinsumos on-farm.
Aqui, você aprende na ordem certa, o que realmente faz diferença no resultado final — do laboratório ao campo.
O que você vai aprender:
ETAPA 1: Entendendo o microrganismo
Você aprende a identificar corretamente fungos e bactérias utilizados como bioinsumos, entendendo:
-
Como cada microrganismo funciona
-
Como se comporta no laboratório e no campo
-
O que observar visualmente para evitar erros.
ETAPA 2: Produzir bioinsumos com método
Você aprende a estruturar a produção on-farm com critério microbiológico, abordando:
Qualidade da água
Meios de cultura e inóculos
Tempo correto de multiplicação
POPs, organização e treinamento da equipe.
ETAPA 3: Garantir qualidade e segurança na aplicação
Você aprende como:
Implementar controle de qualidade on-farm
Coletar e enviar amostras corretamente
Aplicar bioinsumos com segurança no campo
Evitar prejuízos por falhas invisíveis.
👉 Estas imagens representam exemplos de grupos de microrganismos abordados no manual.

O que você será capaz de fazer após estudar este manual
✓ Conhecer os principais microrganismos usados como bioinsumos
✓ Produzir com método e previsibilidade
✓ Reduzir perdas por contaminação
✓ Aplicar bioinsumos com mais segurança no campo
Por que este manual é diferente?
✔ Linguagem acessível ao agricultor
✔ Base científica aplicada à realidade do agricultor
✔ Apresenta fotos de colônias dos microrganismos
✔ Alinhado à Lei 15.070/2024
✔ Foco em segurança e boas práticas
👉 Este não é um material genérico.
É um manual construído a partir de anos de laboratório, campo e consultoria direta com agricultores brasileiros.
Quem escreveu este manual
Dra. Ligiane Aparecida Florentino
Engenheira Agrônoma, Mestre em Microbiologia Agrícola e Doutora em Microbiologia e Bioquímica do Solo, com Pós-Doutorado em Microbiologia Agrícola.
Atua há mais de 25 anos conectando ciência e campo, auxiliando agricultores na produção segura de bioinsumos on-farm.
Ao longo de mais de 25 anos, acompanhei de perto os erros mais comuns na produção de bioinsumos on-farm — e é exatamente isso que este manual ajuda você a evitar.
🔒 O que você recebe ao adquirir este manual
✔ Manual completo em PDF
Conteúdo técnico e aplicado para produzir bioinsumos on-farm com segurança e boas práticas.
✔ Material complementar de cultivo
PDF com pH, temperatura e oxigênio ideais para os principais microrganismos.
✔ Planilha de planejamento da produção
Ferramenta prática para organizar pré-cultivo, multiplicação e aplicação, reduzindo erros e perdas.
✔ Modelo de POP para higienização dos biorreatores
✔ Acesso imediato pela Hotmart
👉 Tudo pensado para a realidade do agricultor.